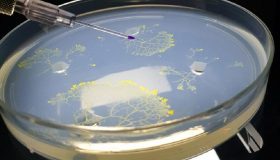

Етикет: Памет
Дефицитът на флаваноли е свързан с влошаването на паметта, вследствие на възрастта
Проучване разкрива, че диета с ниско съдържание на флаваноли допринася за свързаната с възрастта загуба на памет, докато добавянето на флаваноли подобрява паметта при...
Здравословният начин на живот – особено питателната диета – забавят влошаването на паметта при...
10-годишно проучване на възрастни китайци на възраст над 60 години показва, че здравословният начин на живот, по-специално питателната диета, е свързана със забавянето на...
Доктор от Харвард обяснява кои са храните полезни за вашия мозък
Може би сте чували за „храни за мозъка“ или „суперхрани“. За тях се говори навсякъде в интернет, особено сред влиятелните лица в социалните медии....
Искате да се върнете към моменти на щастие в миналото? Ето кои звуци могат...
Според ново проучване, звукът е това, което връща нашите най-добрите спомени - пред очите и дори може да ни накара да усетим миризма, свързана...
Памет без мозък: Как мухълът Physarum polycephalum взема интелигентни решения
Как мухълът Physarum polycephalum взема интелигентни решения без централна нервна система. Наличието на памет за минали събития ни позволява да вземаме по-интелигентни решения за бъдещето....
Подобриха паметта на човека с метод, използван от древните гърци
Когнитивните невролози са сканирали мозъка на 23 „световни шампиони по памет“ в опит да разкрият какво се крие зад техните невероятни подвизи на паметта....